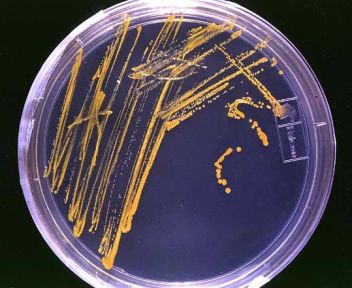

Google oslavil výročí vynálezce Petriho misky
Dnes si sami můžete na počítači využití Petriho misek prohlédnout. Stačí když navštívíte Google.cz a spustíte animaci nad vyhledávacím políčkem.
Nejdříve uvidíte jak se misky připravují a pak můžete lupou zkoumat jejich obsah.
V případě, že bys se vám na hlavní stránce Google již Petriho misky nezobrazily, tak se na ně můžete podívat v archivu Google.com/doodles.
Ve spolupráci s Trigon plus
autor:
Diskuze k článku „Google oslavil výročí vynálezce Petriho misky“